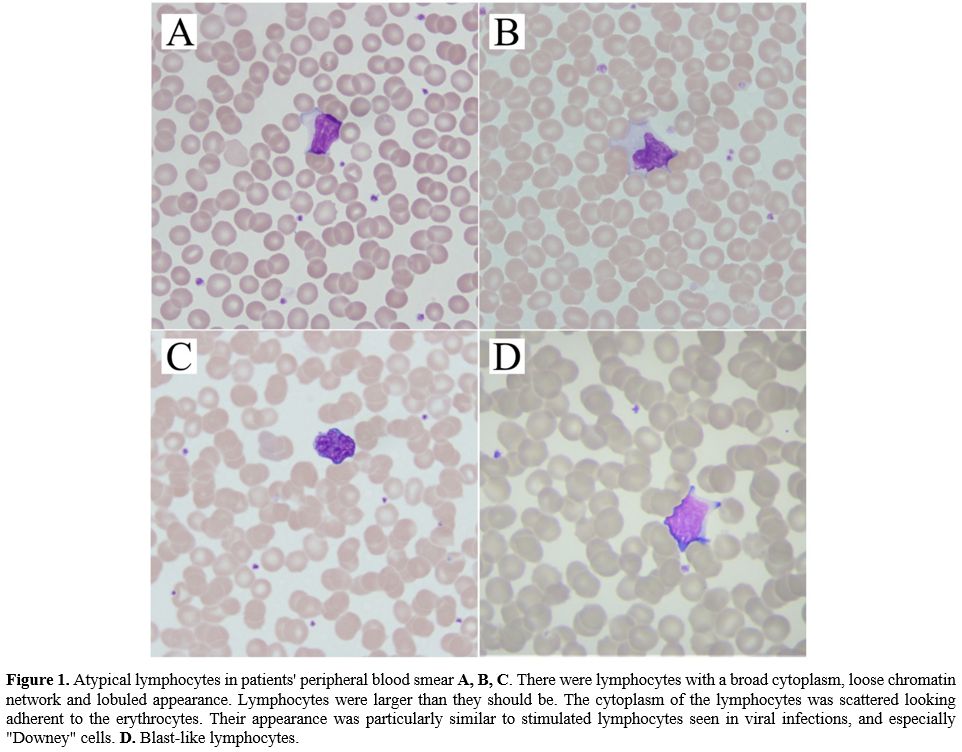
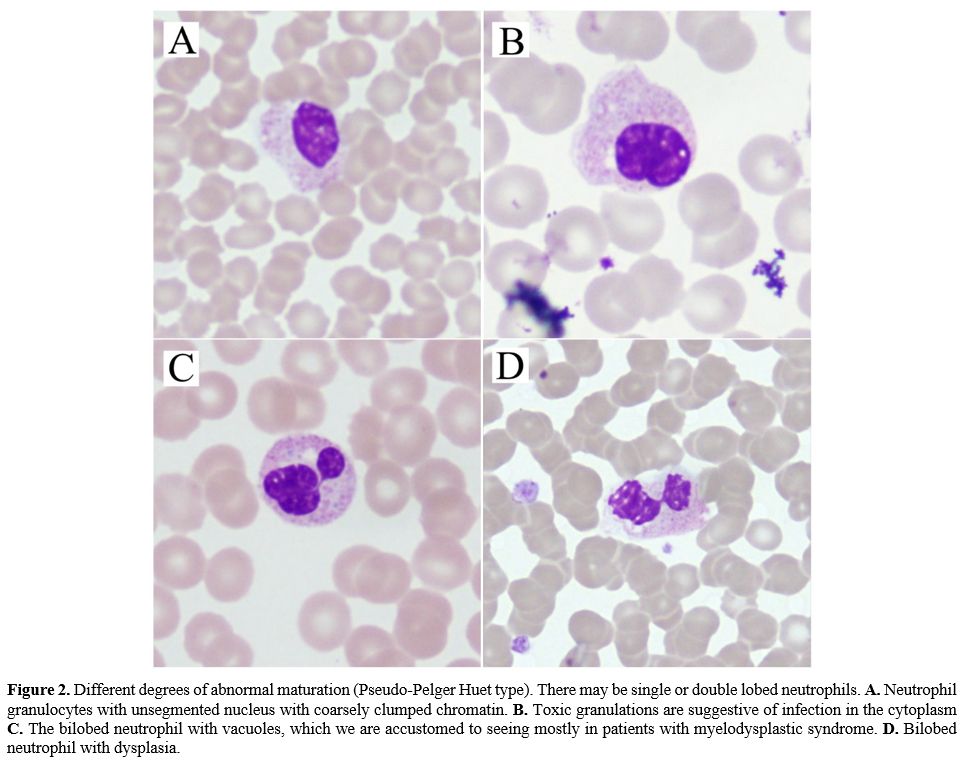
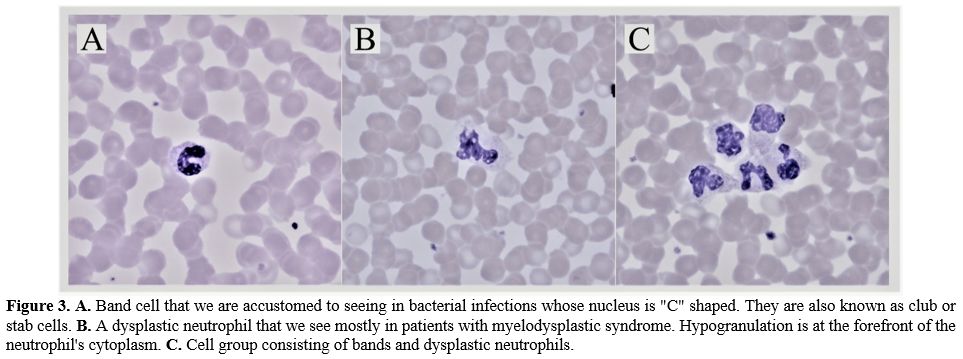
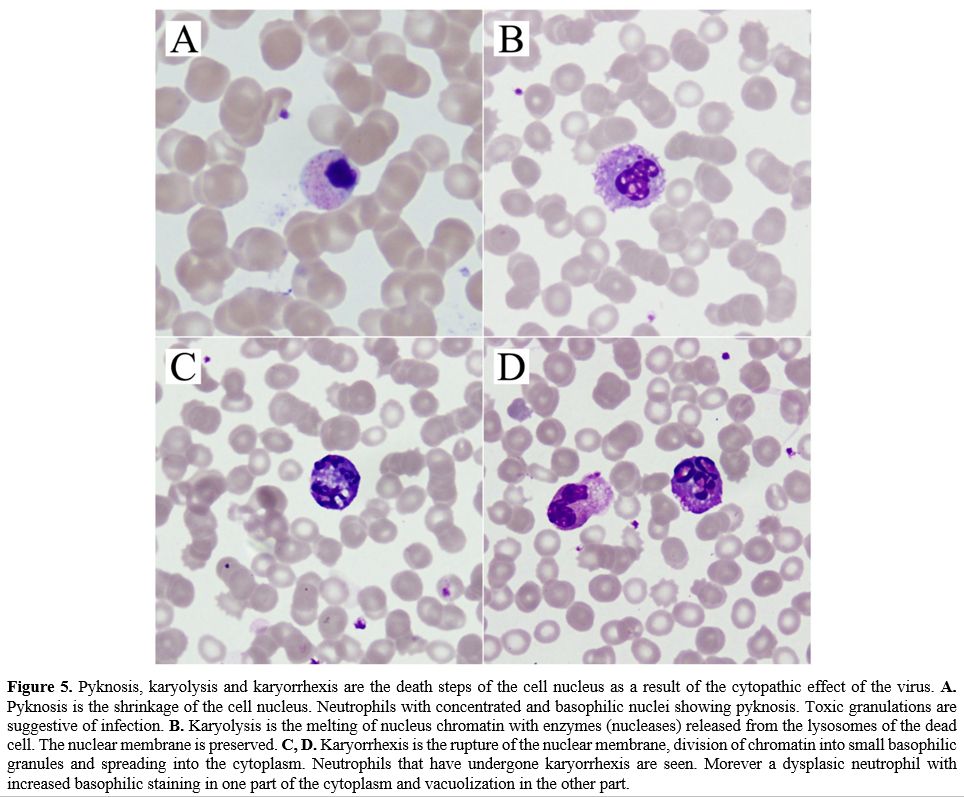

Ilhami Berber1, Ozlem Cagasar2, Ahmet Sarici1, Nurcan Kirici Berber3, Ismet Aydogdu4, Ozkan Ulutas5, Asli Yildirim6, Harika Gozde Gozukara Bag7 and Leman Acun Delen8.
1 Inonu University Adult Hematology Department, Malatya / Turkey.
2 Malatya Training and Research Hospital, Department of Infectious Diseases, Malatya / Turkey.
3 Malatya Training and Research Hospital, Chest Diseases Department, Malatya / Turkey.
4 Celal Bayar University Adult Hematology Department, Manisa / Turkey.
5 Inonu University Internal Medicine Department, Malatya / Turkey.
6 Malatya Training and Research Hospital, Department of Medical Oncology, Malatya / Turkey.
7 Inonu University Biostatistics Department, Malatya / Turkey.
8 Malatya Training and Research Hospital, Anesthesiology Department, Malatya / Turkey.
Correspondence to: Ozkan
Ulutas, Associate Professor of Internal Medicine. Inonu University,
Turgut Özal Medical Center, Internal Medicine Department,
Malatya/TURKEY. Tel.: +90 422 341 06 60, Fax.:+90 850 297 90 03.
E-mail:
drozkanulutas@yahoo.com
Published: January 1, 2021
Received: September 15, 2020
Accepted: December 10, 2020
Mediterr J Hematol Infect Dis 2021, 13(1): e2021009 DOI
10.4084/MJHID.2021.009
This is an Open Access article distributed
under the terms of the Creative Commons Attribution License
(https://creativecommons.org/licenses/by-nc/4.0),
which permits unrestricted use, distribution, and reproduction in any
medium, provided the original work is properly cited.
|
|
Abstract
Background:
Data about the morphological changes in peripheral blood smears during
COVID-19 infection and their clinical severity association are limited.
We aimed to examine the characteristics of the cells detected in the
pathological rate and/or appearance and whether these findings are
related to the clinical course by evaluating the peripheral blood smear
at the time of diagnosis in COVID-19 patients.
Methods:
Clinical features, laboratory data, peripheral blood smear of fifty
patients diagnosed with COVID-19 by PCR was evaluated at diagnosis.
Peripheral smear samples of the patients were compared with the age and
sex-matched 30 healthy controls. Pictures were taken from the patient's
peripheral blood smear. Patients were divided into two
groups.
Mild and severe stage patient groups were compared in terms of
laboratory data and peripheral smear findings. The relationship between
the laboratory values of all patients and the duration of
hospitalization was analyzed.
Results:
The number of segmented neutrophils and eosinophils were low,
pseudo-Pelger-Huet, pseudo-Pelger-Huet/mature lymphocyte ratio,
atypical lymphocytes, monocytes with vacuoles, bands, and pyknotic
neutrophils rates were higher in the peripheral blood smear of the
patient group (p <0.05). Increased pseudo-Pelger-Huet anomaly,
pseudo-Pelger Huet/mature lymphocyte ratio, a decreased number of
mature lymphocytes, and eosinophils in peripheral blood smear were
observed in the severe stage patients (p <0.05). A negative
correlation was observed between hospitalization duration and mature
lymphocyte and monocytes with vacuoles rates (p <0.05).
Conclusion:
A peripheral blood smear is an inexpensive, easily performed, and rapid
test. Increased Pseudo-Pelger-Huet anomaly/mature lymphocyte rate
suggests a severe stage disease, while high initial mature lymphocyte
and monocytes with vacuoles rates at the time of diagnosis may be an
indicator of shortened duration of hospitalization.
|
Introduction
Coronaviruses
(CoV) are a large family of viruses that cause diseases in a broad
clinical spectrum, from mild common flu infection to Middle East
Respiratory Syndrome (MERS-CoV) and Severe Acute Respiratory Syndrome
(SARS-CoV-1). The new coronavirus disease was first identified as a
result of research in a group of patients who developed respiratory
tract symptoms such as fever, cough, shortness of breath in Wuhan
Province in China at the end of December.[1,2]
On
02/11/2020, the disease caused by a new coronavirus (SARS-CoV-2) was
officially named COVID-19 by the World Health Organization (WHO).[3]
SARS-CoV-2 was initially detected in people working at the seafood and
animal market in this region. It spread from person to person and other
cities such as Hubei, and finally, other world countries.[4,5] Ultimately, it was declared a
pandemic disease by WHO on March 11, 2020.[3]
Viral
infections can change the cell numbers and morphology in the peripheral
blood smear. In addition to numerical changes like leukocytosis,
leukopenia, neutrophilia, neutropenia, monocytosis, monocytopenia,
lymphocytosis, lymphopenia, thrombocytopenia, it can also change the
morphology of the cells like atypical lymphocyte, inclusion bodies,
vacuolization. Atypical lymphocytes, which are sometimes difficult to
distinguish from the blasts, can be seen in many viral infections such
as infectious mononucleosis, viral hepatitis, cytomegalovirus
infections, human immunodeficiency virus infections (HIV), and COVID-19
infection.[6,7] Some viruses can
produce
intracytoplasmic or intranuclear inclusions when they grow either in
vivo and in vitro (in cell cultures). It is possible to see them easily
under a microscope in painted smears. The number of monocytes with
vacuoles may increase with infections, malignancies, alcohol use, toxic
situations as evidence of active immune response.[8,9,10]
Pyknosis and karyorrhexis are known as death phases of cells and appear
with rounding and opacity of infected cell nuclei due to the virus
infection's cytopathic effect. The cells' band size (club, stab) varies
between 10 and 16 microns, and their nuclei are undivided, seen like a
horseshoe. Their numbers may increase in infections and bleeding. Two
or single lobe neutrophils that have defects of lobulation or
maturation are called pseudo-Pelger-Huet anomalies. The hereditary type
of pseudo-Pelger-Huet is autosomal dominant, but the acquired type is
mostly associated with different pathological states like
myelodysplastic syndrome, certain infections, and drug use.[11,12,13]
While
it is impossible to obtain the presence, percentage, or counts of some
cells with a unique pathological appearance by complete blood count,
they can be easily distinguished by peripheral blood smear. Those cells
with prognostic significance in several diseases are illustrated as a
pseudo-Pelger-Huet anomaly in myelodysplastic syndrome, smudge cells in
chronic lymphocytic leukemia, and vacuolar lymphocytes in metabolic
diseases.[14,15,16] Cells
suggesting viral infection
in peripheral blood smears in COVID-19 patients are limited, and a
small number of studies showed an association between peripheral blood
smear findings and clinical severity of the disease. In our study, we
aimed to define cells with the pathological appearance and/or rates in
peripheral blood smear at the time of diagnosis and whether these cells
are associated with clinical severity in COVID-19 patients.
Materials and Methods
Patients.
The data of laboratory-confirmed COVID-19 patients diagnosed between
June 01, 2020, and June 20, 2020, were analyzed retrospectively in the
Malatya Training and Research Hospital.
Fifty COVID-19 patients
and 30 healthy controls were included in this study. Peripheral blood
smear samples of the patient group were compared with the healthy
controls initially. All peripheral blood smear samples were obtained
with the same techniques. The patient group was divided into two as
mild and severe disease groups. Both mild and severe disease groups
were compared in terms of age, gender, leukocytes, neutrophils,
hemoglobin, hematocrit, lymphocytes, eosinophils, monocytes, platelets
in complete blood count, segmental, bands, pseudo-Pelger-Huet
anomalies, mature lymphocytes, pseudo-Pelger Huet /mature lymphocytes,
atypical lymphocytes, monocytes, monocytes with vacuoles, eosinophils,
basophils, pyknotic neutrophils in peripheral blood smear, duration of
hospitalization and mortality rates. The relationship between the
baseline laboratory characteristics of the patients and the duration of
hospitalization was also examined.
Laboratory
Analysis.
Real-time reverse transcriptase-polymerase chain reaction (PCR) tests
for SARS-CoV-2 RNA were performed using nasopharyngeal swabs. Total
nucleic acid extraction of nasopharyngeal swabs of viral isolates was
performed using a biospeedy and coyote extraction system (Bioeksen ltd
and Coyote Bioscience ltd.). Real-time PCR (RT-PCR) assays for
SARS-CoV-2 RNA detection were performed using Biospeedy COVID-19
RT-qPCR Detection Kit (Bioeksen, Istanbul, Turkey).
Disease
Severity.
Patients were divided into four stages according to their clinical
status. Stage 1; asymptomatic (without any symptoms), stage 2;
symptomatic without lung involvement, stage 3; symptomatic with lung
involvement, stage 4; acute respiratory distress syndrome, intubated,
multiorgan failure.[17,18,19]
Stage 1,2 patients were classified as a mild stage, and 3,4 patients
were classified as a severe stage.
Collection
of Peripheral Smear.
For cases meeting the study criteria, the Wright stained smear was
subsequently examined by two hematologists (Dr. Aydogdu I, Dr. Berber
I). Hematologists evaluated peripheral blood smear preparations blinded
in terms of patients, controls, and laboratory results of the subjects.
Peripheral blood smears of the patients were prepared with a blood
sample taken from an EDTA tube. A peripheral blood smear was performed,
using the same technique, in 30 healthy controls. One hundred leukocyte
counts were performed on each peripheral blood smear. Pictures were
taken from the peripheral blood smears of the patients (Figure 1-5).
Lymphocytes divided into two groups; mature lymphocytes and atypical or
reactive lymphocytes, which have an eccentric nucleus, dark basophilia
of the cytoplasm and pale sunflower region adjacent to the nucleus,
cells similar to the plasma cell, and single-core lymphocyte-monocyte,
dark basophilia or vacuoles in the cytoplasm and sometimes with
nucleoli (Figure 1).
Neutrophils were divided into three subgroups; (I) the nuclei composed
of 3-4 segments connected with thin chromatin as segmented neutrophils,
(II) single-lobe or bilobed neutrophils as a pseudo-Pelger-Huet anomaly
(Figure 2),
(III) cell size
ranging from 10 to 16 microns with horseshoe-shaped undivided nuclei
resembling the C, U, S letters as bands (club, stab) (Figure 3).
The cells with a nucleus having features like loose chromatin network,
curved, resembling kidney and located in the middle or edge of the
cell, with gray-blue colored cytoplasm, and thin granules were
evaluated monocytes. Monocytes containing vacuoles in their cytoplasm
were recorded as monocytes with vacuoles (Figure 4).
Pyknosis is the shrinkage of the cell nucleus. Karyolysis is the
melting of nucleus chromatin with enzymes (nucleases) released from the
dead cell's lysosomes. Karyorrhexis is the rupture of the nuclear
membrane, chromatin division into small basophilic granules, and
spreading into the cytoplasm (Figure
5). Cells with a bilobed nucleus and large pink granules
in their cytoplasm were recorded as eosinophils.
|
Figure
1. Atypical lymphocytes in patients' peripheral blood smear A, B, C.
There were lymphocytes with a broad cytoplasm, loose chromatin network
and lobuled appearance. Lymphocytes were larger than they should be.
The cytoplasm of the lymphocytes was scattered looking adherent to the
erythrocytes. Their appearance was particularly similar to stimulated
lymphocytes seen in viral infections, and especially "Downey" cells. D. Blast-like
lymphocytes. |
|
Figure 2.
Different degrees of abnormal maturation (Pseudo-Pelger Huet type).
There may be single or double lobed neutrophils. A. Neutrophil
granulocytes with unsegmented nucleus with coarsely clumped chromatin. B. Toxic
granulations are suggestive of infection in the cytoplasm C. The bilobed
neutrophil with vacuoles, which we are accustomed to seeing mostly in
patients with myelodysplastic syndrome. D. Bilobed
neutrophil with dysplasia.
|
|
Figure
3. A.
Band cell that we are accustomed to seeing in bacterial infections
whose nucleus is "C" shaped. They are also known as club or stab cells.
B. A
dysplastic neutrophil that
we see mostly in patients with myelodysplastic syndrome.
Hypogranulation is at the forefront of the neutrophil's cytoplasm. C. Cell group
consisting of bands and dysplastic neutrophils. |
 |
Figure
4. A, B.The
monocytes with vacuoles that generally increased during infections.
Vacuoles are often considered to be evidence of the fight against
infectious agents. C.
A picture to show the severity of vacuolization in patients. D. Beside a monocyte
with vacuole, a neutrophil with dysplasia and vacuole. |
|
Figure
5. Pyknosis,
karyolysis and karyorrhexis are the death steps of the cell nucleus as
a result of the cytopathic effect of the virus. A.
Pyknosis is the shrinkage of the cell nucleus. Neutrophils with
concentrated and basophilic nuclei showing pyknosis. Toxic granulations
are suggestive of infection. B.
Karyolysis is the melting of nucleus chromatin with enzymes (nucleases)
released from the lysosomes of the dead cell. The nuclear membrane is
preserved. C, D.
Karyorrhexis
is the rupture of the nuclear membrane, division of chromatin into
small basophilic granules and spreading into the cytoplasm. Neutrophils
that have undergone karyorrhexis are seen. Morever a dysplasic
neutrophil with increased basophilic staining in one part of the
cytoplasm and vacuolization in the other part. |
Statistical
Analysis.
Data analysis was performed using IBM SPSS v26 software. Descriptive
statistics were used to summarize data. Variables were assessed for
normal distribution with the Kolmogorov Smirnov test. Categorical data
were presented as number-percentages, and numerical data were presented
as median, minimum, and maximum. Differences between categorical
variables were analyzed with the Chi-Square test, and numeric variables
were compared with the Mann-Whitney U test. A two-sided p-value ≤ 0.05
was considered statistically significant.
Roc analysis was
performed to find a cut-off point for differential morphological
aspects between mild and severe disease stages.
Spearman
correlation coefficient correlates with hospital stay length and
baseline laboratory values and morphological findings in the peripheral
blood smears.
The study was approved by the research ethics
committee of Inonu University, Faculty of Medicine (date/reference
number: 30-06-2020/892). All analyses were performed in accordance with
the principles of the Declaration of Helsinki.
Results
Patients
and healthy controls were similar in terms of age and sex. In the
peripheral blood smear, the number of segmented neutrophils,
eosinophils were low; the band, pseudo-Pelger-Huet, atypical
lymphocytes, monocytes with vacuoles, pseudo-Pelger-Huet/mature
lymphocyte ratio, and pyknotic neutrophils were higher in the patient
group (Table 1)
(p<0,05).
 |
Table
1. Clinical features, laboratory values, and peripheral blood smear
findings of all the patients and healthy controls.
|
Twenty-four
patients
in the mild-stage and 26 patients in the severe stage were compared in
terms of clinical features and laboratory values (Table 2).
No statistically significant difference was found between mild and
severe stage in terms of complete blood count. In peripheral blood
smears of severe-stage patients, it was observed that the number of
mature lymphocytes and eosinophils decreased, and pseudo-Pelger-Huet
anomaly, pseudo-Pelger Huet anomaly/mature lymphocytes ratio increased
when compared with the mild stage group (p< 0.05). The number of
band cells, mature monocytes, and monocytes with vacuoles were
increased in the severe stage, although they did not reach the
statistical significance (p>0.05). The length of hospital stay
was
significantly higher in severe-stage patients (p<0.05). A
cut-off
point for differential morphological aspects between the mild and
severe stages of the disease was tried to be determined by Roc
analysis. Unfortunately, a specific value could not be found because
the area under the curve (AUC) was not significant. While none patients
died in the mild stage group, two patients died in the severe stage
(p> 0.05).
 |
Table
2. Comparison of
laboratory values, peripheral blood smear findings, and clinical
features of Mild and severe stage patients.
|
Laboratory
values of
all patients were compared with the duration of hospitalization. A
significant positive correlation between a longer hospitalization
duration and an increased number of neutrophils in the complete blood
count was observed. A negative correlation between the duration of
hospitalization and lymphocyte count in hemogram, mature lymphocyte,
and monocytes with vacuoles rates in peripheral blood smear was
observed (p<0.05) (Table
3).
 |
Table
3. Correlation
analysis between the length of hospital stay, and baseline laboratory
characteristics, morphological findings of the patients.
|
Discussion
This
study shows that an increased pseudo-Pelger Huet, pseudo-Pelger Huet/
mature lymphocyte ratio, and decreased mature lymphocyte and eosinophil
rates in peripheral blood smear were found in COVID patients with
severe diseases stage. Moreover, at the onset of the disease, patients
with an increased number of mature lymphocytes and monocytes with
vacuoles in the peripheral blood smear had a short hospitalization
duration.
In
general, viral infections are known to be manifested by atypical
lymphocytes, inclusion bodies, monocytes with vacuoles, and pyknosis in
leukocytes of the peripheral blood smear. Information about the
morphological changes of COVID-19 infection in peripheral blood smears
and the significance of these changes on the disease's clinical course
is limited.
Dan
Zhang et al. reported COVID-19 induces readily detectable morphological
and inflammation-related phenotypic changes in peripheral blood
monocytes, whose entity correlates with patient outcome. They detected
an increased number of larger, atypical, vacuolated monocytes, not
generally seen in healthy individuals' peripheral blood smear. We
confirmed the presence of the same vacuolated monocytes in our previous
study.[20] Delphine Gérard et al.
reported that
peripheral blood film examination revealed a highly pleomorphic
atypical lymphocyte population, and many cells were large (15–30 µm).
The cytoplasm was sometimes granulated. Cytoplasmic basophilia was
sometimes generalized and sometimes confined to the cytoplasmic
margins. Some cells had one or more nucleoli and could have been mixed
with blast cells.[6] Alia
Nazarullah et al. reported
peripheral blood examination findings in SARS-CoV-2 infection. They
showed that the pseudo-Pelger-Huet anomaly was recorded in all cases of
COVID-19, affecting more than 5% of granulocytes in most cases.[21]
Yunus Murat Akcabelen et al. reported dysplastic changes in peripheral
blood cells of COVID-19 patients. We also observed atypical
lymphocytes, pseudo-Pelger-Huet anomaly, and dysplastic changes in
peripheral blood cells in a previous study.[22]
Maryame
et al. found neutrophil granulocyte with dysmorphic morphology marked
by hypogranular cytoplasm and hyposegmented nucleus, atypical
eosinophils containing multiple vacuoles, rare, activated lymphocytes,
and large monocytes in some peripheral blood films in COVID-19
patients.[23] They did not show
any association of
these changes with the clinical course of the disease. In this study,
we observed a large number of dysplasia, hypolobular, hypergranular
neutrophils, and a small number of hypogranular neutrophils. It was
observed that atypical lymphocytes increased compared to the control
group but did not significantly affect hospitalization duration. Cantu
MD et al. reported blue-green neutrophil and monocyte cytoplasmic
inclusions in peripheral blood smear of critically ill SARS-CoV-2
positive patients; these inclusions were still present 20 days after
the diagnosis of COVID-19. They showed that blue-green inclusions might
correlate with short-term mortality.[24]
Similar inclusions were found by us in one patient's lymphocytes with a
severe stage (Figure 1H),
showing that they are not specific for myeloid lineage. Alterations of
granulocytes can be different in COVID-19; Christian Salib et al.
showed hypersegmented granulocytes infected patients;[25]
in our study, we found that pseudo-Pelger-Huet anomalies were
significantly present, especially in severe patients. Similarly, Gina
Zini et al. reported morphological anomalies of circulating blood cells
in COVID-19 patients. These anomalies were unsegmented or bilobular
nuclei like pseudo-Pelger-Huet, hypergranular with basophilic
cytoplasm, hypogranular and agranular areas, multiple vacuoles in
neutrophil granulocyte, immature circulating cells with blasts-like
reticular chromatin and rare thin azurophilic granules, likely
pre-apoptotic, circulating apoptotic neutrophil, apoptotic cells with
blue cytoplasm, of possible lymphocyte origin, large polyploid reactive
lymphocyte with hyperbasophilic cytoplasm, giant vacuolated platelets.[26]
Anupam Mitra et al. reported a leukoerythroblastic reaction in a
46-year-old previously healthy female with COVID-19 infection. In
peripheral blood smear, they found nucleated erythroid, rare blast,
with prominent nucleoli and immature chromatin pattern, a left-shifted
myeloid series with immature promyelocytes and metamyelocytes, and
occasional monocytes.[27] Chuan
Qin et al. reported
452 patients with COVID-19 infection, 286 of whom were diagnosed as a
severe infection. Severe cases tend to have lower lymphocyte counts,
higher leukocyte counts, neutrophil-lymphocyte ratio (NLR), and lower
percentages of monocytes, eosinophils and basophils.[28]
Man Kong et al. reported a higher level of neutrophil-to-lymphocyte is
associated with severe COVID-19.[29]
Ai-Ping Yang et al. reported that elevated neutrophil-to-lymphocyte
ratio could be considered independent biomarkers for indicating poor
clinical outcomes.[30]
The
cells we examined in peripheral blood smear were morphologically
similar to the others published in the literature. We did not see a
leukoerythroblastic reaction in any of our patients. Especially in
severe patients, we found a higher number of band cells and a lower
number of segmented neutrophils, but these results did not reach
statistically significant levels, and that could be due to increased
cytokine levels in the severe stage. We observed an increased
pseudo-Pelger Huet anomaly, pseudo-Pelger Huet anomaly/mature
lymphocyte ratio, decreased mature lymphocytes, and eosinophils rates
in the severe stage patients. Impaired immunity due to decreased
lymphocyte count and an increase in dysfunctional neutrophil count due
to pseudo-Pelger Huet anomaly may be the answer to why these patients
are admitted to the hospital at an severe stage.
The
morphological abnormalities in all cell lines may be a prognosticator
for increased mortality of this disease. There was a negative
correlation between monocytes with vacuoles, lymphocyte counts, and
duration of hospitalization. These observations can be explained by the
degree of suppressing the SARS-CoV-2 virus through inflammatory
mechanisms on hematopoiesis and the immune system that reduce these
cells' number.
Our
study has some strengths. To our knowledge, this is the first article
showing an association between the stages, the clinical course of the
disease, and cell morphology in peripheral blood smears of COVID-19
patients. Our study has several limitations: the low number of the
study population with a low mortality rate did not permit establishing
a relationship between peripheral blood smear findings and disease
prognosis. Moreover, we could not examine pathological cells'
disappearance because the peripheral blood smear samples could not be
taken during the follow-up period. Increased pseudo-Pelger Huet anomaly
and pseudo-Pelger Huet/mature lymphocyte ratio in peripheral blood
smear may suggest the advanced stage disease. Increased monocytes with
vacuoles and mature lymphocytes may indicate shorter duration of
hospitalization. As a result, peripheral blood smear is an inexpensive,
easily performed, and rapid test. Peripheral blood smear assessment at
the time of diagnosis in COVID-19 patients can provide information
about the stage and severity of the disease and the length of hospital
stay. Studies with larger number of patients are needed in order to
increase the reliability of this information and associate the findings
of peripheral smear with the prognosis of the disease.
References
- Li Q, Guan X, Wu P, Wang
X, Zhou L, Tong Y, Ren R,
Leung KSM, Lau EHY, Wong JY, Xing X, Xiang N, Wu Y, Li C, Chen Q, Li D,
Liu T, Zhao J, Liu M, Tu W, Chen C, Jin L, Yang R, Wang Q, Zhou S, Wang
R, Liu H, Luo Y, Liu Y, Shao G, Li H, Tao Z, Yang Y, Deng Z, Liu B, Ma
Z, Zhang Y, Shi G, Lam TTY, Wu JT, Gao GF, Cowling BJ, Yang B, Leung
GM, Feng Z. Early Transmission Dynamics in Wuhan, China, of Novel
Coronavirus-Infected Pneumonia. N Engl J Med. 2020 March
26;382(13):1199-1207. https://doi.org/10.1056/NEJMoa2001316
PMid:31995857 PMCid:PMC7121484
- Pal
M, Berhanu G, Desalegn C, Kandi V. Severe Acute Respiratory Syndrome
Coronavirus-2 (SARS-CoV-2): An Update. Cureus. 2020;12(3):e7423.
Published 2020 March 26. https://doi.org/10.7759/cureus.7423
- World
Health Organization Press Conference. The World Health Organization
(WHO) Has Officially Named the Disease Caused by the Novel Coronavirus
as COVID-19. Available online: (accessed on May 18 2020).
- Chan
JF, Yuan S, Kok KH, To KK, Chu H, Yang J, Xing F, Liu J, Yip CC, Poon
RW, Tsoi HW, Lo SK, Chan KH, Poon VK, Chan WM, Ip JD, Cai JP, Cheng VC,
Chen H, Hui CK, Yuen KY. A familial cluster of pneumonia associated
with the 2019 novel coronavirus indicating person-to-person
transmission: a study of a family cluster. Lancet. 2020 Feb
15;395(10223):514-523. https://doi.org/10.1016/S0140-6736(20)30154-9
- Zhu
N, Zhang D, Wang W, Li X, Yang B, Song J, Zhao X, Huang B, Shi W, Lu R,
Niu P, Zhan F, Ma X, Wang D, Xu W, Wu G, Gao GF, Tan W; China Novel
Coronavirus Investigating and Research Team. A Novel Coronavirus from
Patients with Pneumonia in China, 2019. N Engl J Med. 2020 February
20;382(8):727-733. https://doi.org/10.1056/NEJMoa2001017
PMid:31978945 PMCid:PMC7092803
- Gérard D, Henry S,
Thomas B. SARS-CoV-2: a new aetiology for atypical lymphocytes. Br J
Haematol. 2020 Jun;189(5):845. https://doi.org/10.1111/bjh.16730
PMid:32311762 PMCid:PMC7264674
- El
Jamal SM, Salib C, Stock A, Uriarte-Haparnas NI, Glicksberg BS,
Teruya-Feldstein J, Dembitzer FR, Nadkarni GN, Firpo-Betancourt A.
Atypical lymphocyte morphology in SARS-CoV-2 infection. Pathol Res
Pract. 2020 Sep;216(9):153063. doi: 10.1016/j.prp.2020.153063. Epub
2020 June 10. https://doi.org/10.1016/j.prp.2020.153063
PMid:32825937 PMCid:PMC7284261
- Ponder E., Ponder R.V.
Cytology of polymorphonuclear leucocyte in toxic conditions. J Lab Clin
Med. 1942; 28:316-322.
- GORDIN R. Toxic
granulation in leukocytes; development and relation to cloudy swelling.
Acta Med Scand Suppl. 1952;270:1-50.
- Jordans
G.H.W. The familial occurrence of fat containing vacuoles in the
leucocytes diagnosed in 2 brothers suffering from dystrophia musculorum
progressiva. Acta Med Scand. 1953;145:419-423. https://doi.org/10.1111/j.0954-6820.1953.tb07038.x
PMid:13079655
- Harald T, Heinz D,
Torsten H. Color Atlas of Hematology. 2004.
- Löffler H, Rastetter J,
Haferlach T. Atlas of Clinical Hematology. Sixth Revised Edition. 2005
- Aydogdu I, Kuku I, Kaya
E, Gödekmerdan A. Kan Hastalıkları Atlası. 2003
- Tassin
F, Dewé W, Schaaf N, Herens C, Ravoet C, Albert A, Beguin Y, Paulus JM.
A four-parameter index of marrow dysplasia has predictive value for
survival in myelodysplastic syndromes. Leuk Lymphoma. 2000
Feb;36(5-6):485-96. https://doi.org/10.3109/10428190009148396
PMid:10784393
- Gogia
A, Raina V, Gupta R, Gajendra S, Kumar L, Sharma A, Kumar R,
Vishnubhatla S. Prognostic and predictive significance of smudge cell
percentage on routine blood smear in chronic lymphocytic leukemia. Clin
Lymphoma Myeloma Leuk. 2014 Dec;14(6):514-7. https://doi.org/10.1016/j.clml.2014.02.007
PMid:24656596
- Anderson
G, Smith VV, Malone M, Sebire NJ. Blood film examination for vacuolated
lymphocytes in the diagnosis of metabolic disorders; retrospective
experience of more than 2,500 cases from a single centre. J Clin
Pathol. 2005 Dec;58(12):1305-10. https://doi.org/10.1136/jcp.2005.027045
PMid:16311352 PMCid:PMC1770783
- Lauer
SA, Grantz KH, Bi Q, Jones FK, Zheng Q, Meredith HR, Azman AS, Reich
NG, Lessler J. The Incubation Period of Coronavirus Disease 2019
(COVID-19) From Publicly Reported Confirmed Cases: Estimation and
Application. Ann Intern Med. 2020 May 5;172(9):577-582. https://doi.org/10.7326/M20-0504
PMid:32150748 PMCid:PMC7081172
- Ferguson
N.M, Laydon D., Nedjati-Gilani G., Imai N., Ainslie K., Baguelin M.,
Bhatia S., Boonyasiri A., Cucunubá Z., Cuomo-Dannenburg G., Dighe A.,
Dorigatti I., Fu H., Gaythorpe K., Green W., Hamlet A., Hinsley W.,
Okell L.C., Elsland S.V., Thompson H., Verity R., Volz E., Wang H.,
Wang Y., Walker P.G.T., Walters C., Winskill P., Whittaker C., Donnelly
C.A., Riley S., Ghani A.C. Impact of non-pharmaceutical interventions
(NPIs) to reduce COVID-19 mortality and healthcare demand. Imperial
College COVID-19 Response Team. 2020;10:77482. URL: https://www.imperial.ac.uk/media/imperial-college/medicine/sph/ide/gida-fellowships/Imperial-College-COVID19-NPI-modelling-16-03-2020.pdfm
- Liu
Y., Yan L.M., Wan L., Xiang T.X., Le A., Liu J.M., Peiris M., Poon
L.L.M., Zhang W. Viral dynamics in mild and severe cases of COVID-19.
The Lancet Infectious Diseases. 2020. https://doi.org/10.1016/S1473-3099(20)30232-2
- Zhang
D., Guo R., Lei L., Liu H., Wang Y., Wang Y., Dai T., Zhang T., Lai Y.,
Wang J. Liu Z., He A., O'Dwyer M., Hu J. COVID‐19 infection induces
readily detectable morphologic and inflammation-related phenotypic
changes in peripheral blood monocytes. Journal of Leukocyte Biology.
2020. https://doi.org/10.1002/JLB.4HI0720-470R
PMid:33040384 PMCid:PMC7675546
- Nazarullah
A., Liang C., Villarreal A., Higgins R.A., Mais D.D. Peripheral Blood
Examination Findings in SARS-CoV-2 Infection. American journal of
clinical pathology. 2020; 154(3), 319-329. https://doi.org/10.1093/ajcp/aqaa108
PMid:32756872 PMCid:PMC7454310
- Akcabelen
Y.M., Gurlek G.D., Yaralı N. Dysplastic Changes of Peripheral Blood
Cells in COVID-19 Infection. Turk J Haematol. 2020 August 19. https://doi.org/10.4274/tjh.galenos.2020.2020.0342
PMid:32812414
- Ahnach
M, Ousti F, Nejjari S, Houssaini MS, Dini N. Peripheral Blood Smear
Findings in COVID-19. Turk J Haematol. 2020 June 26. https://doi.org/10.4274/tjh.galenos.2020.2020.0723
PMCid:PMC7702645
- Cantu
MD, Towne WS, Emmons FN, Mostyka M, Borczuk A, Salvatore SP, Yang HS,
Zhao Z, Vasovic LV, Racine-Brzostek SE. Clinical significance of
blue-green neutrophil and monocyte cytoplasmic inclusions in SARS-CoV-2
positive critically ill patients. Br J Haematol. 2020
Jul;190(2):e89-e92. https://doi.org/10.1111/bjh.16882
PMid:32453859 PMCid:PMC7283650
- Salib C,
Teruya-Feldstein J. Hypersegmented granulocytes and COVID-19 infection.
Blood. 2020;135(24):2196. https://doi.org/10.1182/blood.2020006483
PMid:32526026 PMCid:PMC7290095
- Zini
G, Bellesi S, Ramundo F, d'Onofrio G. Morphological anomalies of
circulating blood cells in COVID-19. Am J Hematol. 2020
Jul;95(7):870-872. https://doi.org/10.1002/ajh.25824
PMid:32279346 PMCid:PMC7262044
- Mitra
A, Dwyre DM, Schivo M, Thompson GR 3rd, Cohen SH, Ku N, Graff JP.
Leukoerythroblastic reaction in a patient with COVID-19 infection. Am J
Hematol. 2020 Aug;95(8):999-1000. https://doi.org/10.1002/ajh.25793
PMid:32212392 PMCid:PMC7228283
- Qin
C., Zhou L., Hu Z., Zhang S., Yang S., Tao Y., Xie C., Ma K., Shang K.,
Wang W., Tian D.S. Dysregulation of immune response in patients with
COVID-19 in Wuhan, China. Clinical Infectious Diseases. 2020. https://doi.org/10.1093/cid/ciaa248
PMid:32161940 PMCid:PMC7108125
- Kong
M, Zhang H, Cao X, Mao X, Lu Z. Higher level of
neutrophil-to-lymphocyte is associated with severe COVID-19. Epidemiol
Infect. 2020 July 9;148:e139. https://doi.org/10.1017/S0950268820001557
PMid:32641174 PMCid:PMC7360950
- Yang
A.P., Liu J., Tao W., Li H.M. The diagnostic and predictive role of
NLR, d-NLR and PLR in COVID-19 patients. International
immunopharmacology, 2020. 106504. https://doi.org/10.1016/j.intimp.2020.106504
PMid:32304994 PMCid:PMC7152924
[TOP]